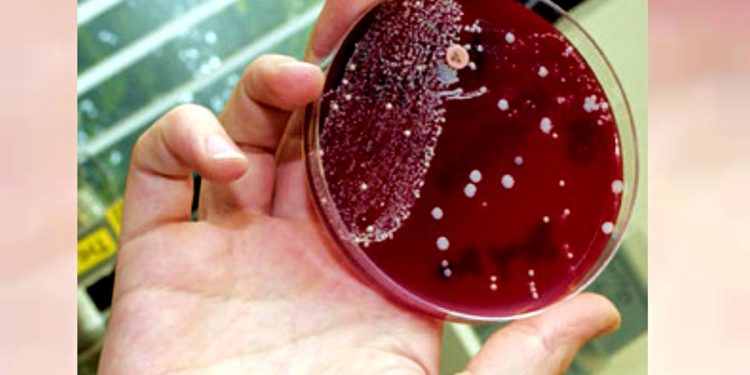
Sebabkan Kematian Usai 48 Jam Terinfeksi, Bakteri Pemakan Daging Gegerkan Jepang

Teras Merdeka – Kasus infeksi bakteri mematikan menggegerkan masyarakat Jepang. Bakteri tersebut dapat menginfeksi manusia dan menyebabkan kematian dalam waktu 48 jam.
Menurut CNN International dan National Post, Jepang memang telah mengalami peningkatan dalam jumlah kasus “flesh-eating bacteria” alias bakteri pemakan daging.
Sebenarnya secara resmi penyakit ini disebut dengan sindrom syok toksik streptokokus (STSS). Hingga 9 Juni lalu, ada 1.019 kasus STSS dengan angka kematian hingga 30%-nya.
“Dalam data yang sama disebutkan bahwa ada 77 orang telah meninggal akibat STSS dari Januari hingga Maret,” bunyi laporan itu, dikutip Kamis (20/6/2024).
“Dengan tingkat infeksi saat ini, jumlah kasus di Jepang bisa mencapai 2.500 pada tahun ini,” ujar seorang profesor penyakit menular di Tokyo Women’s Medical University, Ken Kikuchi.
Penjelasan Mengenai STSS
STSS merupakan infeksi bakteri yang jarang namun dapat berkembang serius ketika menyebar ke jaringan dalam dan aliran darah.
Pasien awalnya menderita demam, nyeri otot, dan muntah-muntah, namun gejalanya dapat dengan cepat mengancam nyawa dengan tekanan darah rendah, pembengkakan, dan kegagalan banyak organ saat tubuh mengalami syok.
“Bahkan dengan pengobatan pun, STSS bisa mematikan,” tulis Pusat Pengendalian dan Pencegahan Penyakit AS (CDC).
“Dari 10 orang yang mengidap STSS, sebanyak tiga orang akan meninggal akibat infeksi tersebut,” tambah data itu.
Penyebab STSS
Sebagian besar kasus STSS disebabkan oleh bakteri streptokokus grup A (GAS). Biasanya GAS menyebabkan demam dan infeksi tenggorokan pada anak-anak.
Dalam keadaan yang jarang terjadi, ini dapat menjadi iniasif ketika bakteri menghasilkan racun yang memungkinkannya mengakses aliran darah. Hal itu kemudian menyebabkan penyakit serius seperti STSS.
GAS juga dapat menyebabkan “fasciitis nekrotikans” disebut juga pemakan daging. Infeksi bakteri serius ini mampu menghancurkan jaringan di bawah kulit, yang dapat menyebabkan hilangnya anggota tubuh.
Namun, sebagian besar pasien yang tertular penyakit tersebut memiliki faktor kesehatan lain yang dapat menurunkan kemampuan tubuh mereka untuk melawan infeksi. Contohnya seperti kanker atau diabetes.
Institut Penyakit Menular Nasional Jepang merilis penilaian risiko telah meningkat sejak Juli 2023. Mereka yang rentan terutama di bawah 50 tahun.
Cara Menghindari STSS
Health Canada juga menghimbau untuk menjaga kebersihan tangan sebelum dan sesudah makan, batuk atau bersin bahkan ketika menggunakan kamar mandi. Peningkatan ventilasi dalam ruangan juga penting.
Penggunaan masker dan jarak sosial juga bisa mencegah infeksi. Namun penggunaan alkohol dan narkoba menjadi faktor risiko lain penyebaran.
Sebagai informasi, kasus lain juga terlihat di Eropa. Invasif GAS (iGAS), dilaporkan mewabah di lima negara Eropa sejak 2022, dan menyebabkan 10 kematian anak-anal.
Di Kanada, 13 anak dilaporkan meninggal akibat iGAS, termasuk STSS, antara 1 Oktober 2023 dan 31 Mei 2024. Selama periode ini, 1.510 kasus telah dilaporkan, meningkat 33 persen dibandingkan ke musim sebelumnya.